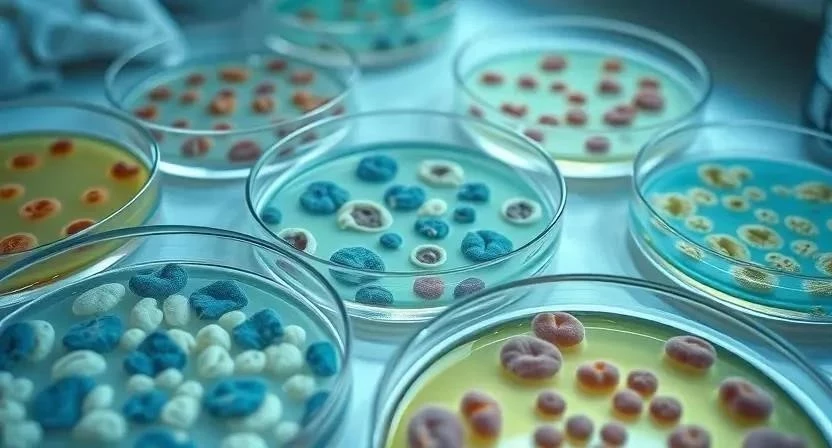

Задумывались ли вы, как врачи точно определяют, какая бактерия вызывает вашу болезнь? Современная лабораторная диагностика предлагает широкий спектр методов для выявления бактериальных инфекций. От простых микроскопических исследований до высокотехнологичной ПЦР – каждый метод имеет свои преимущества и недостатки. Точная диагностика – это первый и важнейший шаг к эффективному лечению и быстрому выздоровлению.
Лабораторная диагностика – это комплекс исследований, направленных на выявление возбудителя инфекции, определение его характеристик и чувствительности к антибиотикам. Это позволяет врачу подобрать наиболее эффективную схему лечения и избежать ненужного применения препаратов.
Методы лабораторной диагностики
Существует множество методов лабораторной диагностики бактериальных инфекций, каждый из которых имеет свои особенности. Основные методы включают бактериологические исследования, серологические методы и ПЦР-диагностику. Выбор метода зависит от типа инфекции, стадии заболевания и доступности оборудования.
Бактериологические методы
Бактериологические методы являются «золотым стандартом» диагностики бактериальных инфекций. Они основаны на выделении и культивировании бактерий из биологического материала (кровь, моча, мокрота, мазок и т.д.). После выделения бактерии определяют ее вид, чувствительность к антибиотикам и другие характеристики.
Я помню, как однажды у моего сына был сильный кашель. Врач назначил посев мокроты, чтобы определить, какая бактерия вызвала воспаление. Результаты показали наличие пневмококка, и нам назначили антибиотик, к которому эта бактерия была чувствительна. Уже через несколько дней сыну стало лучше.
- Посев на питательные среды: Бактерии помещают в специальную среду, содержащую питательные вещества, необходимые для их роста.
- Микроскопия: Бактерии рассматривают под микроскопом для определения их формы, размера и других морфологических характеристик.
- Определение чувствительности к антибиотикам (антибиотикограмма): Бактерии подвергают воздействию различных антибиотиков, чтобы определить, какие из них наиболее эффективны.
- Идентификация бактерий: Определение вида бактерии с помощью биохимических тестов и других методов.
- Оценка количества бактерий: Определение концентрации бактерий в образце.
- Определение факторов вирулентности: Выявление генов, отвечающих за способность бактерии вызывать заболевание.
- Молекулярно-генетические методы: Использование ПЦР и других методов для идентификации бактерий и определения их генотипа.

Серологические методы
Серологические методы основаны на выявлении антител в крови пациента. Антитела – это белки, которые вырабатываются иммунной системой в ответ на вторжение бактерий. Обнаружение антител позволяет определить, контактировал ли пациент с бактерией и есть ли у него иммунитет к ней.
Однажды, когда я работал в больнице, мы проводили серологическое исследование на хламидиоз. У многих пациентов были повышены титры антител, что указывало на перенесенную или текущую инфекцию.
- Реакция пассивной гемагглютинации (РПГА): Определение антител путем реакции антиген-антитело, в которой происходит агглютинация эритроцитов.
- Реакция непрямой гемагглютинации (РНГА): Аналогична РПГА, но используется для определения антигенов.
- Иммуноферментный анализ (ИФА): Определение антител или антигенов с помощью фермента, связанного с антителом.
- Реакция нейтрализации: Определение антител, способных нейтрализовать действие бактериального токсина.
- Реакция комплемента: Определение антител путем реакции антиген-антитело, в которой происходит связывание комплемента.
- Агглютинация латекса: Определение антигенов или антител с помощью латексных частиц, покрытых антителами или антигенами.
- Проточная цитометрия: Определение антител, связанных с клетками, с помощью лазерного сканирования.
ПЦР-диагностика
ПЦР-диагностика (полимеразная цепная реакция) – это современный метод, который позволяет выявить ДНК бактерий в биологическом материале. ПЦР является очень чувствительным и специфичным методом, что позволяет обнаружить даже небольшое количество бактерий.
Я помню, как в лаборатории, где я работал, ПЦР-диагностика стала незаменимым инструментом для выявления микоплазмы и уреаплазмы. Этот метод позволял быстро и точно определить наличие инфекции и назначить соответствующее лечение.
- Выделение ДНК: ДНК выделяют из биологического материала.
- Амплификация ДНК: ДНК многократно копируют с помощью фермента полимеразы.
- Детекция ДНК: Обнаружение амплифицированной ДНК с помощью специальных красителей или зондов.
- Мультиплексная ПЦР: Одновременное выявление нескольких бактерий в одном образце.
- Реальновременная ПЦР: Определение количества ДНК в образце в режиме реального времени.
- ПЦР с обратной транскрипцией: Выявление РНК-содержащих вирусов.
- ПЦР-секвенирование: Определение последовательности ДНК бактерий для идентификации и определения их генотипа.

Современные методы диагностики
Современные методы диагностики бактериальных инфекций включают масс-спектрометрию, секвенирование нового поколения и другие инновационные технологии. Эти методы позволяют быстро и точно идентифицировать бактерии, определять их чувствительность к антибиотикам и прогнозировать исход заболевания.
Интерпретация результатов
Интерпретация результатов лабораторных анализов должна проводиться врачом с учетом клинической картины заболевания и других факторов. Важно помнить, что результаты анализов не являются диагнозом, а лишь помогают врачу поставить правильный диагноз и назначить эффективное лечение. Обязательно проконсультируйтесь с врачом для получения квалифицированной медицинской помощи.
FAQ
Вопрос: Что такое антибиотикограмма?
Ответ: Антибиотикограмма – это исследование, которое определяет чувствительность бактерий к различным антибиотикам.
Вопрос: Как подготовиться к сдаче анализов на бактериальные инфекции?
Ответ: Подготовка зависит от типа анализа. Обычно рекомендуется не принимать антибиотики за несколько дней до сдачи анализа и соблюдать правила сбора биологического материала.
Вопрос: Сколько времени занимает проведение лабораторных исследований?
Ответ: Время проведения исследований зависит от метода и лаборатории. Обычно результаты бактериологических исследований доступны через несколько дней, а результаты ПЦР-диагностики – через несколько часов.
Таблица 1: Сравнение методов диагностики
| Метод | Чувствительность | Специфичность | Скорость | Стоимость |
|---|---|---|---|---|
| Бактериологический посев | Высокая | Высокая | Медленная (несколько дней) | Низкая |
| Серологические методы | Средняя | Средняя | Средняя (несколько часов) | Низкая |
| ПЦР-диагностика | Очень высокая | Очень высокая | Быстрая (несколько часов) | Высокая |
Таблица 2: Интерпретация результатов анализов
| Показатель | Значение | Интерпретация |
|---|---|---|
| Количество бактерий в посеве | >10^5 КОЕ/мл | Инфекция |
| Титр антител | >1:100 | Инфекция или перенесенная инфекция |
| Наличие ДНК бактерий в ПЦР | Положительный | Инфекция |